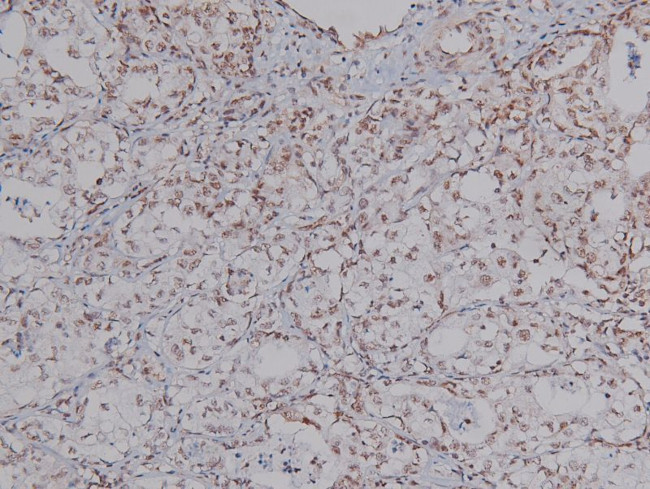
Phospho-CtIP (Ser327) Antibody in Immunohistochemistry (Paraffin) (IHC (P))

Search
Invitrogen
Phospho-CtIP (Ser327) Polyclonal Antibody
{{$productOrderCtrl.translations['antibody.pdp.commerceCard.promotion.promotions']}}
{{$productOrderCtrl.translations['antibody.pdp.commerceCard.promotion.viewpromo']}}
{{$productOrderCtrl.translations['antibody.pdp.commerceCard.promotion.promocode']}}: {{promo.promoCode}} {{promo.promoTitle}} {{promo.promoDescription}}. {{$productOrderCtrl.translations['antibody.pdp.commerceCard.promotion.learnmore']}}
图: 1 / 4
Phospho-CtIP (Ser327) Antibody (PA5-105748) in IHC (P)




Please note: We are reviewing Western blot images included in the antibody testing data in our catalog, including those provided by third parties. Unless expressly labeled or annotated as “raw-unedited”, Western blot images included in the antibody testing data in our catalog may have been edited, optimized or otherwise adjusted for presentation.
产品信息
PA5-105748
种属反应
宿主/亚型
分类
类型
抗原
偶联物
形式
浓度
规格
纯化类型
保存液
内含物
保存条件
运输条件
RRID
产品详细信息
Antibody detects endogenous levels of CtIP only when phosphorylated at Ser327.
靶标信息
CtIP, a 125 kD protein, was originally found interacting with a transcription repressor, CtBP, through the PLDLS motif (CtBP-Interacting Protein) thus suggested a role in transcription. Studies have shown that CtIP also interacts with BRCA1 protein through the c-terminus BRCT domains also suggested that CtIP is a potential tumor suppressor. This CtIP-BRCA1 interaction can be disrupted by DNA damaging agents including UV or gamma-irradiation. Li et al (Nature 406, 210 - 215 (2000)) have shown that ATM phosphorylates CtIP at serine residues 664 and 745, and mutation of these sites abrogates the dissociation of BRCA1 from CtIP, resulting in persistent repression of BRCA1-dependent induction of GADD45 upon ionizing radiation.
仅用于科研。不用于诊断过程。未经明确授权不得转售。
篇参考文献 (0)
生物信息学
蛋白别名: CtBP-interacting protein; CtIP; DNA endonuclease RBBP8; RBBP-8; Retinoblastoma-binding protein 8; Retinoblastoma-interacting protein and myosin-like; RIM; SAE2; Sporulation in the absence of SPO11 protein 2 homolog
基因别名: 9930104E21Rik; CTIP; RBBP-8; RBBP8; RGD1308872; RIM; SAE2
UniProt ID: (Rat) B1WC58, (Mouse) Q80YR6
Entrez Gene ID: (Rat) 291787, (Mouse) 225182